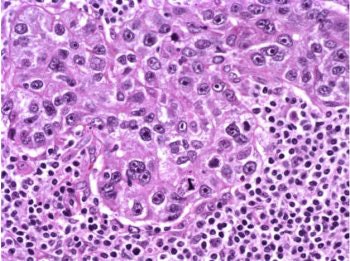

Introduction
Breast cancer is the most common type of cancer among U.S. women regardless of race, age, or ethnicity. The types of various breast cancers are illustrated in table 1 as summarized by the American Cancer Society (2004). Mammography combined with breast self-exam is the most important tool available to women for early detection of breast cancer. Frequently, however, mammography and the breast self-exam are not utilized, and lesions may go undetected for months or even years.
Sadly, it is estimated that 211,240 women will be diagnosed with breast cancer this year according to the National Cancer Institute (2005). Of those it is estimated that 40,410 will die. Several risk factors are important considerations when evaluating patients with possible breast cancer. These risk factors include:
- A first-degree relative with breast cancer (mother, daughter, sister), especially if the cancer developed before menopause or was bilateral
- Early menarche and/or late menopause
- Nulliparity
- Previous personal history of breast cancer
- Prior radiation exposure
- BRCA1 or BRCA2 (autosomal dominant breast cancer susceptibility gene)
A prior biopsy of atypical ductal hyperplasia or lobular carcinoma in situ is also a risk factor for breast cancer. If the patient feels a palpable mass on self-examination, this should also raise concern for breast carcinoma.
Case study
The role of MR mammography, combined with computer-aided detection (DynaCAD, Invivo, Orlando, FL), was illustrated by a case seen recently at Waukesha Memorial Hospital in Waukesha, WI ("Radiography and pathology reports," April 7, 2005, Waukesha Memorial Hospital and Oconomowoc Memorial Hospital, Waukesha, WI).
The patient was a 42-year-old woman who experienced right breast trauma, then subsequently noticed a palpable mass in the upper outer aspect of that breast. The injury occurred in February 2005, and there was no history of breast carcinoma. One month later a bilateral mammogram was performed, and the technologist reported a 5-mm moveable palpable abnormality. Mammography showed multiple benign-appearing masses in the right breast, as well as what appeared to be a lymph node in the left breast measuring approximately 5 mm. CAD was used to additionally assess the full-field digital mammograms.
Bilateral breast ultrasound was also performed during this visit, and demonstrated multiple well-defined anechoic and hypoechoic lesions, which showed through-transmission and no posterior acoustic shadowing. Although through-transmission typically indicates fluid, specifically cysts, some of these lesions were indeterminate. In the left breast, the 5-mm lesion was hypoechoic and had characteristics of a benign intramammary lymph node.
These findings were assigned BI-RADS Category 0: Needs additional imaging evaluation. Table 2 contains additional BI-RADS categories developed by the American College of Radiology for standardization of MR mammography reporting. The results were discussed with the patient and an MRI was recommended.
MR is known for its sensitivity for neoplastic disease and is a powerful diagnostic tool when evaluating patients with metastatic disease and unknown primary cancer. MR mammography can be a valuable adjunct to conventional imaging when x-ray mammography, ultrasound, or physical exam is indeterminate (American Journal of Roentgenology, December 2002, Vol. 17:6, pp. 1493-1501).
To better assess these lesions, which were not impressive on either mammography or ultrasound, an MRI was performed the following week. The MR scan protocol appears in table 3. The patient's previous mammograms and ultrasound examinations were available for comparison.
MR imaging revealed the two lesions, as well as two smaller enhancing masses thought to be intramammary lymph nodes. The left lateral breast had a 3-mm area of enhancement that had benign characteristics.
Time-intensity curves were performed with CAD on the right breast lesions at the 10 o'clock position, 3 cm and 4 cm from the nipple (figure 1 and figure 2, respectively, below). Dr. Christiane Kuhl and colleagues described three basic time-intensity curve types as summarized in table 4. A graphic illustration of the various curves is presented in figure 3 (Radiology, April 1999, Vol. 211:1, pp. 101-110).
![]() |
| Figure 1: Type III curve (below) corresponding to the right breast lesion at the 10 o'clock position, 3 cm from the nipple (above). All images courtesy of Dr. Kathleen Klaas and Bernadette Kaufman. |
![]() |
![]() |
| Figure 2: Similar type III curve (below) corresponding to the right breast lesion at the 10 o'clock position, 4 cm from the nipple (above). |
![]() |
Figure 1 demonstrates a type III curve corresponding to the right breast lesion at the 10 o'clock position, 3 cm from the nipple. In observing the parametric map and subtraction image, the enhancement pattern is suspicious for malignancy. A rapid uptake of contrast is immediately followed by rapid washout. Figure 2 shows similar tissue kinetics for the lesion 4 cm from the nipple.
A cyst aspiration/core biopsy was scheduled for the following day; however, no fluid could be aspirated and an ultrasound-guided core biopsy was performed on the lesions at the 10 o'clock position of the right breast, 3 cm and 4 cm from the nipple. Both specimens were positive for grade III invasive ductal carcinoma. Of the five cores from the specimen at the 10 o'clock position, 3 cm from the nipple, all five samples were positive. Likewise, all six cores from the specimen 4 cm from the nipple were also positive.
The patient underwent a lumpectomy with sentinel node biopsy. The pathology again showed extensive mitoses consistent with grade III invasive ductal carcinoma. Figure 4 (below) shows a representative microscopic section of the mass 4 cm from the nipple at a magnification factor of 100x. Figure 5 is the same area magnified 400x. Figure 6 shows a representative microscopic section from the other mass, which was 3 cm from the nipple magnified 100x. Figure 7 is magnified 400x. The tumors were estrogen receptor- and progesterone receptor-negative. Two sentinel nodes were negative.
![]() |
|
Figure 4: Above, IDC right breast, 10 o'clock, 4 cm from the nipple magnified 100x. Figure 5: Below, IDC right breast, 10 o'clock, 4 cm from the nipple magnified 400x. |
![]() |
Clearly the MR mammography was able to give the clinician a better picture of the tissue kinetics of the suspicious lesions. In the tiered approach to breast imaging that took place here, the physical exam was able to draw attention to the lesions. Conventional mammography and ultrasound were able to confirm the presence of an abnormality, but were unable to characterize it. Yet MR was able to detect changes in tissue kinetics that went unnoticed in other modalities. It is for this reason that MR mammography needs to be part of every breast center's imaging arsenal. Only pathology could confirm cancer.
![]() |
|
Figure 6: Above, IDC right breast, 10 o'clock, 3 cm from the nipple magnified 100x. Figure 7: Below, IDC right breast, 10 o'clock, 3 cm from the nipple magnified 400x. |
![]() |
Discussion
With known sensitivity and the apparent increase in specificity afforded by MR CAD, it would stand to reason that MRI is the best screening tool available, but for many reasons this is untrue. In the example cited above, the patient went through normal channels to get to a diagnosis, and eventually had a biopsy confirming cancer. If MR were the screening tool, it would have been detected even earlier, but in cases of women of normal risk this might not be the case.
An enhancing benign lesion could be biopsied and proved negative after performing one of the most expensive and inaccessible diagnostic imaging examinations in the industry. Dr. Elizabeth Morris stated that in high-risk populations, MR screening mammography resulted in 15% to 25% of patients requiring biopsy; however, only 40% of those were positive. In a normal risk population, many women could potentially be put through the physical and emotional torture of unnecessary biopsy if MR were indeed a screening tool (Applied Radiology, May 2005, Vol. 34:5, pp. 4-9).
It could be said that a false positive is better than a false negative, but the reality of a false positive can have devastating physical and emotional ramifications on certain patient populations, especially younger patients (Annals of Internal Medicine, September 3, 2002, Vol. 175:5, pt.1, pp. 347-360).
The thought of having breast cancer is a horrifying experience for most patients. The grieving and loss associated with the fear of losing a body part, for instance through mastectomy, deeply affects many women. After initial diagnosis, there is a waiting period for subsequent diagnostic studies and every moment that passes exacerbates anxiety in patients diagnosed with breast cancer. When biopsy fails to confirm the diagnosis, some patients are relieved while others live in fear of cancer. The various aspects of emotional response to false-negative results are numerous and complex.
MR mammography is among the most expensive diagnostic tests available. It would entail a prime time 45-minute scheduling slot in the MRI suite, the presence of a technologist and a radiologist, injections of MR contrast, and postprocessing of images.
If this study were ordered on a daily basis for the screening of women of normal risk, it could impede accessibility of the study to women of higher risk, such as those described in the American College of Radiology's Practice Guidelines for the Performance of Magnetic Resonance Imaging (MRI) of the Breast (2005).
Patients with lobular cancer, a family history of breast cancer, a palpable mass, or BRCA1 or BRCA2 genetic mutation are among the groups of women at highest risk. These women can benefit from the increased sensitivity of MRI and the potential value added by MR CAD and MR-guided intervention.
Unfortunately, the insurance companies are the driving force in the way physicians practice medicine. According to the 2004 Tennessee Blue Cross/Blue Shield Reimbursement Guidelines, screening with MR mammography is not a reimbursable procedure. This compounds the problem of high cost and lack of availability, leaving conventional mammography as the gold standard for breast cancer screening.
The U.S. Food and Drug Administration has currently approved only conventional x-ray mammography for breast cancer screening (2005). The roles of other modalities are secondary and reserved for cases that require problem-solving. The sensitivity of mammography is high compared to ultrasound and clinical exam, but low compared to MRI; ultrasound's specificity is higher than MRI, but lower than mammography. So it seems there is no perfect imaging method to both detect and characterize lesion of the breast in women of normal risk who present for screening (Journal of the American Medical Association, September 15, 2004, Vol. 292:11, pp. 1317-1325).
As illustrated in the case study, MRI can play a very important role in the diagnosis and treatment of breast disease. The patient in the example study benefited from a number of advantages MRI has over other modalities. MRI's ability to display images in various planes, subtract images from each other, and display contrast enhancement patterns in both color maps and time-intensity curves helped the radiologist identify and characterize lesions, which were indeterminate by other imaging modalities yet positive for cancer on pathology.
These tools can be particularly helpful for diagnosis and staging, and for follow-up care as well. After a patient has undergone chemotherapy, surgery, radiation therapy, or any combination of the three, MRI can paint a clearer picture of the disease before, during, and after therapy.
The role of MRI for detecting breast cancer is particularly important for women who have a confirmed diagnosis, as it can help stage the disease and potentially spare tissue by defining tumor borders better than other modalities. It can also play an important role in therapy planning as MR-guided wire localizations have become more common. In these situations MR and pathology have confirmed malignancy, and MR is then used to place wires to delineate tumor borders. MR mammography is also useful in evaluating the success of neoadjuvant therapy (AJR, June 2005, Vol. 184:6, pp. 1774-1781).
Some patients wish to try chemotherapy prior to excision of a lesion in hopes of sparing breast tissue. Chemotherapy prior to surgery can decrease tumor size, limiting the amount of tissue excised from the breast, and can result in a better cosmetic outcome.
Conclusion
Current literature supports the theory that while MRI of the breast may lack specificity, the addition of CAD to the MR mammography protocol can decrease interpretation time and add confidence to the diagnosis. Additionally, the availability of open breast coils brings the opportunity to perform MR-guided interventions. If a lesion is found and characterized on MR, a biopsy can be performed immediately to confirm it. The diagnostic imaging community may never find the elusive one-stop-shopping method for breast imaging and diagnosis, but for the time being, MR mammography has taken the lead, primarily for high-risk patients.
By Dr. Kathleen K. Klaas and Bernadette M. Kaufman
AuntMinnie.com contributing writers
February 9, 2006
Dr. Kathleen Klaas is director of breast imaging at Waukesha Memorial Hospital in Waukesha, WI. Bernadette Kaufman is product manager of breast MRI at Invivo of Orlando, FL.
Related Reading
Adding MRS to MRI ups specificity for finding breast lesions, December 16, 2005
Breast MRS proves sensitive to all cancers but not in normal breast tissue, November 27, 2005
PEM turns in solid results for detecting breast malignancies, November 10, 2005
Siemens, Invivo partner on CAD for MRI, November 4, 2005
Copyright © 2006 AuntMinnie.com

.fFmgij6Hin.png?auto=compress%2Cformat&fit=crop&h=100&q=70&w=100)




.fFmgij6Hin.png?auto=compress%2Cformat&fit=crop&h=167&q=70&w=250)











